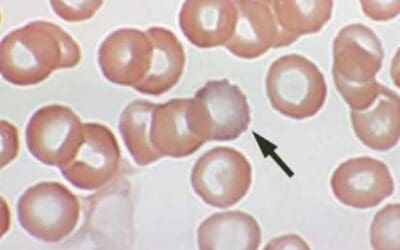
Lead Poisoning

Tachycardia in hematology is critical. Often signals anemia, infection, or treatment issues. Early recognition improves patient outcomes.
Liver and Causes of Hepatomegaly
Hepatomegaly means an enlarged liver, often a sign of underlying conditions like hepatitis, fatty liver, or heart failure. Diagnosis involves physical exams and imaging.
Evans Syndrome
Evans syndrome: Rare autoimmune disorder causing low red blood cells & platelets (AIHA & ITP). Can lead to fatigue, bruising, and bleeding.
Methemoglobinemia
Methemoglobinemia: a blood disorder where hemoglobin can’t carry oxygen. Learn its causes, diagnosis, and treatment in this overview.
Hydrops Fetalis
Explore hydrops fetalis: a severe fetal condition marked by excessive fluid accumulation. Learn its diverse causes, from genetic to infectious.
Hydrops Fetalis
Explore hydrops fetalis: a severe fetal condition marked by excessive fluid accumulation. Learn its diverse causes, from genetic to infectious.
Homocysteine & Hyperhomocysteinemia
Homocysteine is an amino acid linked to an increased risk of heart disease. Elevated levels can be influenced by genetics, diet, and lifestyle.
Vitamin B12 Test: The Essentials
Feeling tired? Check your vitamin B12 levels with a simple blood test. Order your test online today and boost your energy!
Essentials of Folate Blood Test
A folate blood test measures the amount of folate in your blood. Folate is crucial for pregnancy health and overall well-being. Schedule your test today.
Lead Poisoning
Lead poisoning is preventable. Learn about risks in homes, water, and toys. Find out how to test and reduce exposure.
A Guide to At Home Iron Test
At-home iron tests offer a convenient and accessible way to monitor your iron levels and identify potential deficiencies early on
Understanding the Spleen, Splenomegaly & Splenic Pain
The spleen: A key organ for immunity and blood filtration. Learn about its function, location, and related health issues.